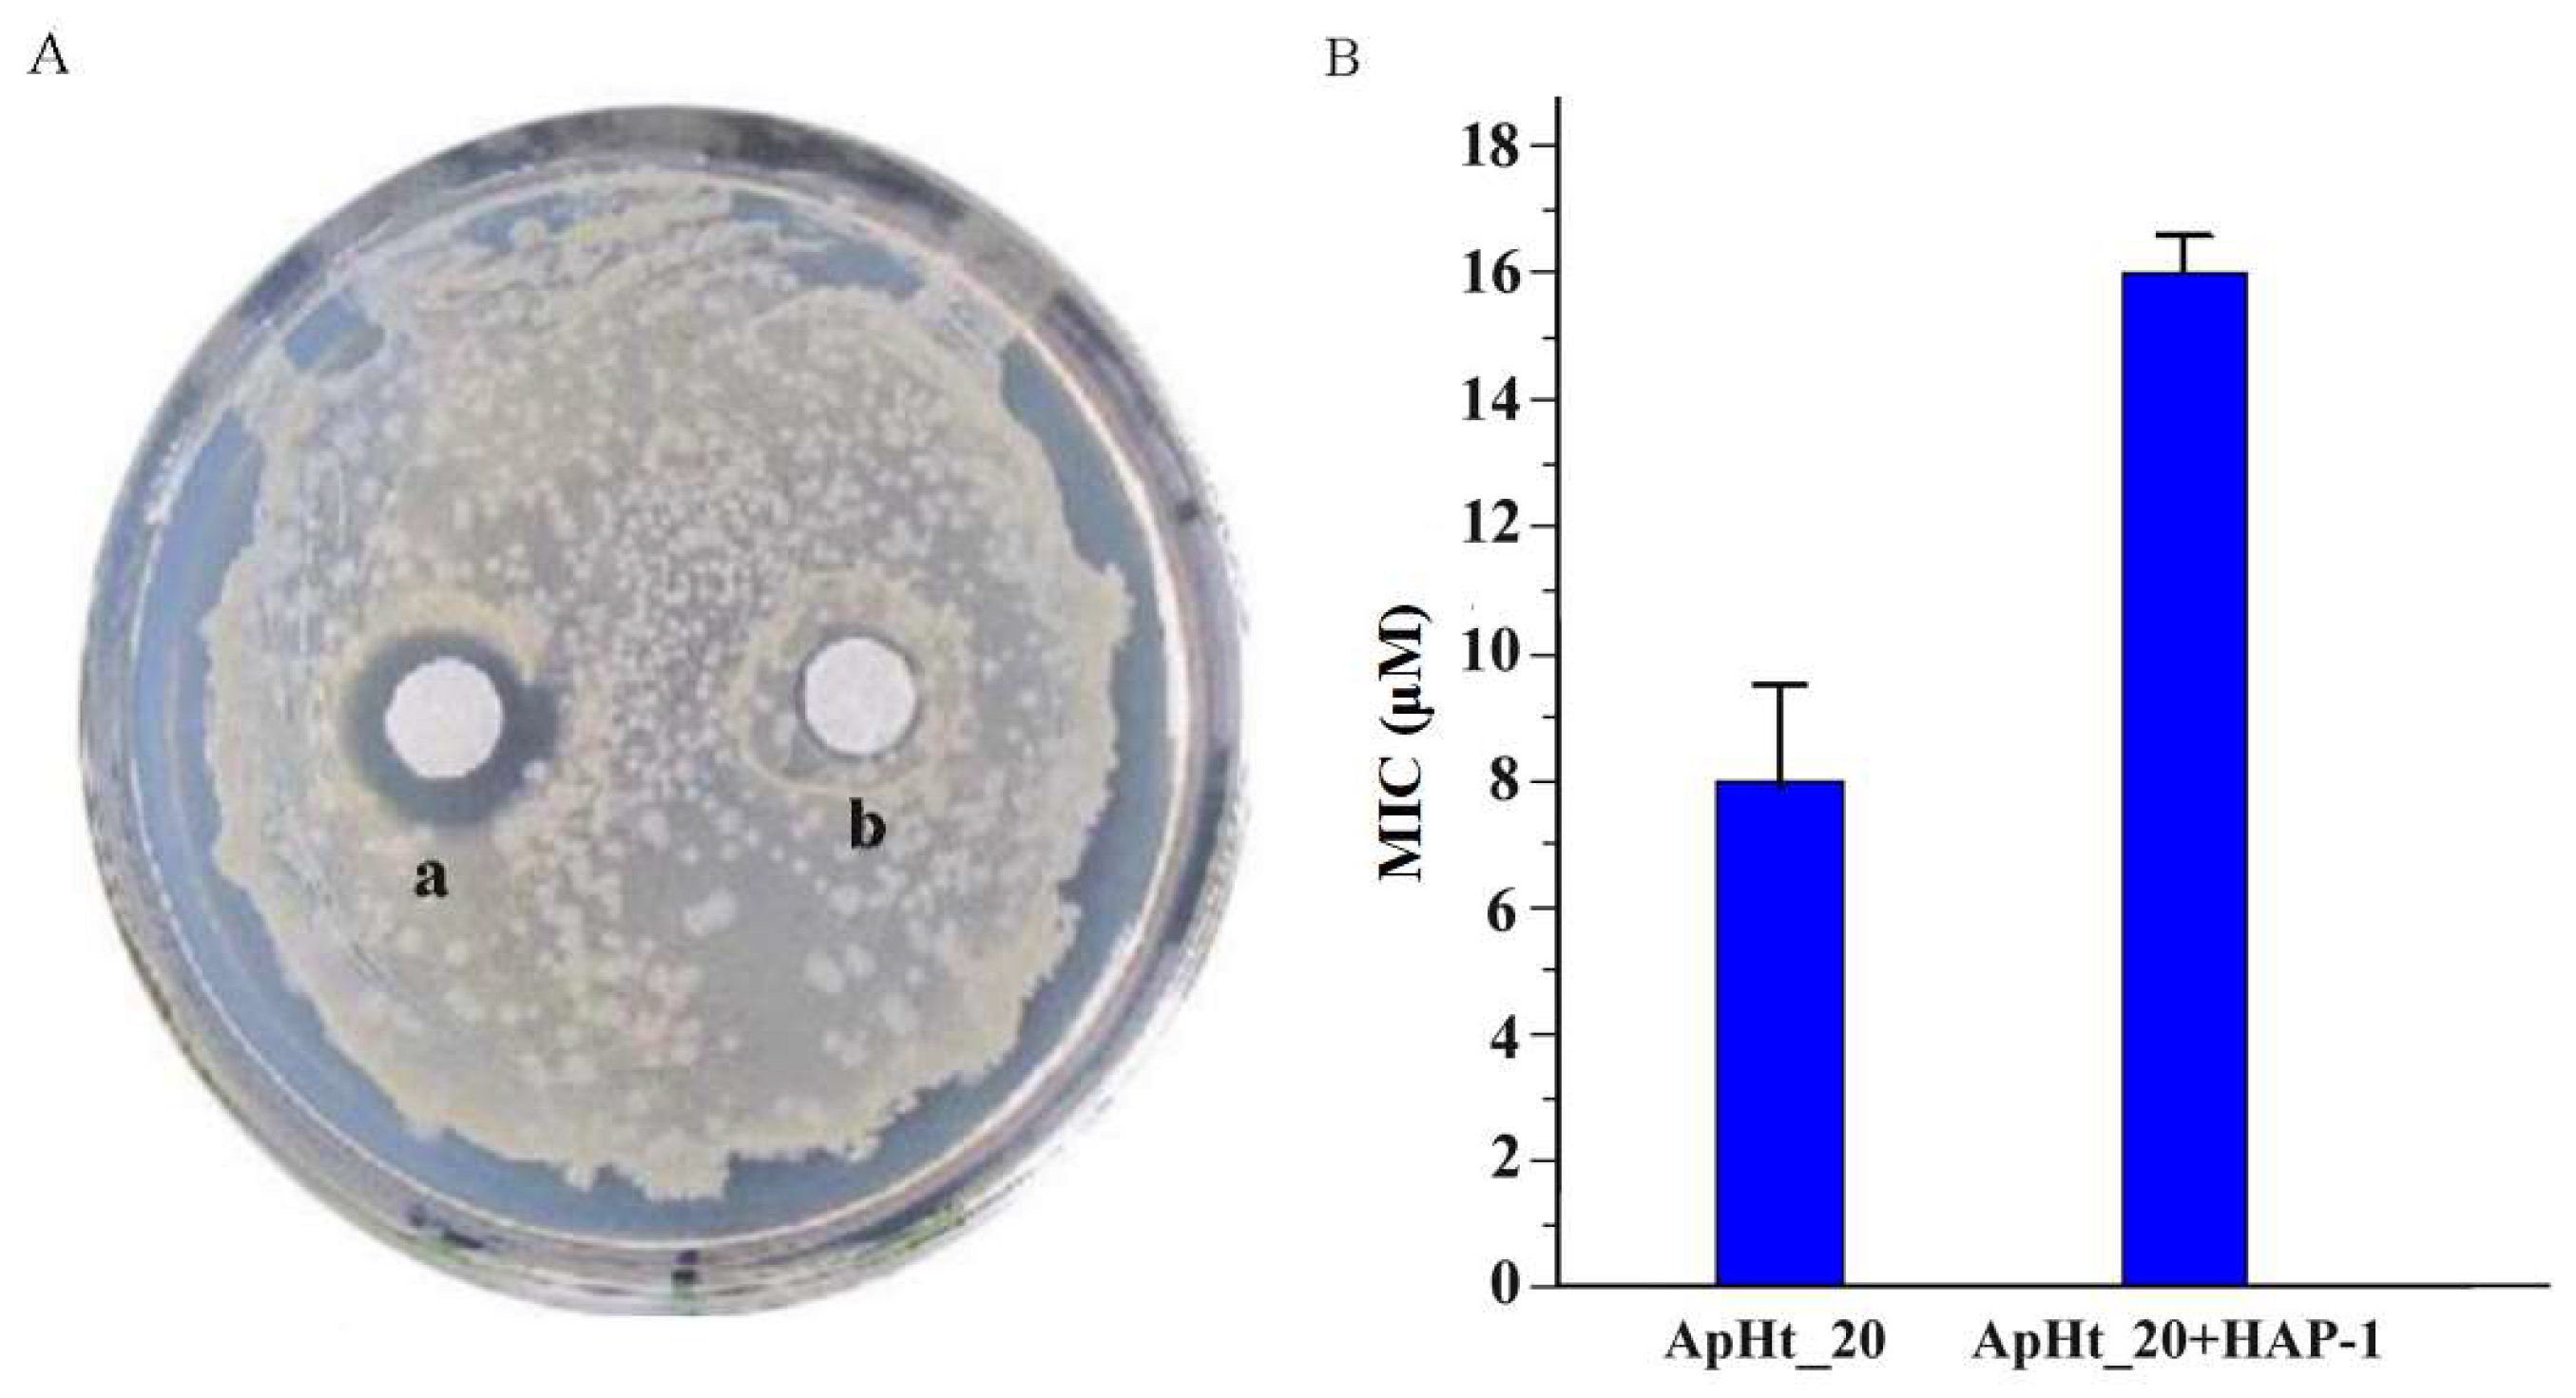
Molecules 23 03314 g003 550

Inhibitory Effect of an Acidic Peptide on the Activity of an Antimicrobial Peptide from the Scorpion Mesobuthus martensii Karsch
Abstract
:1. Introduction
2. Results
2.1. Screening of the cDNA Library Made from the Venom Glands of M. martensii Karsch
2.2. Precursor of HAP-1
2.3. Bioinformatic Characterization of HAP-1
2.4. HAP-1 Markedly Inhibits the Activity of an Antimicrobial Peptide from M. martenssi Karsch
3. Discussion
4. Materials and Methods
4.1. Scorpion Treatment and Purification of Total mRNA from the Venom Glands
4.2. Construction of a cDNA Library
4.3. Screening of the cDNA Library
4.4. Bioinformatics Analysis
4.5. Bacterial Plaque Inhibition Assay
5. Conclusions
Supplementary Materials
Author Contributions
Funding
Conflicts of Interest
References
- He, Q.Y.; He, Q.Z.; Deng, X.C.; Yao, L.; Meng, E.; Liu, Z.H.; Liang, S.P. ATDB: A uni-database platform for animal toxins. Nucleic Acids Res. 2008, 36, 293–297. [Google Scholar] [CrossRef] [PubMed]
- Diego-García, E.; Peigneur, S.; Clynen, E.; Marien, T.; Czech, L.; Schoofs, L.; Tytgat, J. Molecular diversity of the telson and venom components from Pandinus cavimanus (Scorpionidae Latreille 1802): Transcriptome, venomics and function. Proteomics 2012, 12, 313–328. [Google Scholar] [CrossRef] [PubMed]
- Lee, C.W.; Bae, C.; Lee, J.; Ryu, J.H.; Kim, H.H.; Kohno, T.; Swartz, K.J.; Kim, J.I. Solution structure of kurtoxin: A gating modifier selective for Cav3 voltage-gated Ca2+ channels. Biochem. USA 2012, 51, 1862–1873. [Google Scholar] [CrossRef] [PubMed]
- Nie, Y.; Zeng, X.C.; Luo, X.; Wu, S.; Zhang, L.; Cao, H.; Zhou, J.; Zhou, L. Tremendous intron length differences of the BmKBT and a novel BmKBT-like peptide genes provide a mechanical basis for the rapid or constitutive expression of the peptides. Peptides 2012, 37, 150–156. [Google Scholar] [CrossRef] [PubMed]
- Nie, Y.; Zeng, X.C.; Yang, Y.; Luo, F.; Luo, X.; Wu, S.; Zhang, L.; Zhou, J. A novel class of antimicrobial peptides from the scorpion Heterometrus spinifer. Peptides 2012, 38, 389–394. [Google Scholar] [CrossRef]
- Pedraza, E.M.; Possani, L.D. Scorpion beta-toxins and voltage-gated sodium channels: Interactions and effects. Front. Biosci. 2013, 18, 572–587. [Google Scholar]
- Rjeibi, I.; Mabrouk, K.; Mosrati, H.; Berenguer, C.; Mejdoub, H.; Villard, C.; Laffitte, D.; Bertin, D.; Ouafik, L.; Luis, J.; et al. Purification, synthesis and characterization of AaCtx, the first chlorotoxin-like peptide from Androctonus australis scorpion venom. Peptides 2011, 32, 656. [Google Scholar] [CrossRef]
- Zeng, X.C.; Wang, S.; Nie, Y.; Zhang, L.; Luo, X. Characterization of BmKbpp, a multifunctional peptide from the Chinese scorpion Mesobuthus martensii Karsch: Gaining insight into a new mechanism for the functional diversification of scorpion venom peptides. Peptides 2012, 33, 44–51. [Google Scholar] [CrossRef]
- Zeng, X.C.; Wang, S.; Zhu, Y.; Zhu, S.Y.; Li, W.X. Identification and functional characterization of novel scorpion venom peptides with no disulfide bridge from Buthus martensii Karsch. Peptides 2004, 25, 143–150. [Google Scholar] [CrossRef]
- Zeng, X.C.; Zhou, L.L.; Shi, W.X.; Luo, X.S.; Zhang, L.; Nie, Y.; Wang, J.W.; Wu, S.F.; Cao, B.; Cao, H.J. Three new antimicrobial peptides from the scorpion Pandinus imperator. Peptides 2013, 45, 28–34. [Google Scholar] [CrossRef]
- Zeng, X.C.; Zhang, L.; Nie, Y.; Luo, X. Identification and molecular characterization of three new K+-channel specific toxins from the Chinese scorpion Mesobuthus martensii Karsch revealing intronic number polymorphism and alternative splicing in duplicated genes. Peptides 2012, 34, 311–323. [Google Scholar] [CrossRef] [PubMed]
- Gurrola, G.B.; Hernandez-Lopez, R.A.; Rodriguez, D.L.V.R.; Varga, Z.; Batista, C.V.; Salas-Castillo, S.P.; Panyi, G.; del Río-Portilla, F.; Possani, L.D. Structure, function, and chemical synthesis of Vaejovis mexicanus peptide 24: A novel potent blocker of Kv1.3 potassium channels of human T lymphocytes. Biochemistry 2012, 51, 4049–4061. [Google Scholar] [CrossRef]
- Olamendiportugal, T.; Restanocassulini, R.; Umbarila, L.R.; Becerril, B.; Possani, L.D. Functional and immuno-reactive characterization of a previously undescribed peptide from the venom of the scorpion Centruroides limpidus. Peptides 2017, 87, 34–40. [Google Scholar] [CrossRef] [PubMed]
- Zeng, X.C.; Nie, Y.; Luo, X.S.; Wu, S.F.; Shi, W.X.; Zhang, L.; Liu, Y.C.; Cao, H.J.; Yang, Y.; Zhou, J.P. Molecular and bioinformatical characterization of a novel superfamily of cysteine-rich peptides from arthropods. Peptides 2013, 41, 45–58. [Google Scholar] [CrossRef]
- Bao, A.; Zhong, J.; Zeng, X.C.; Nie, Y.; Zhang, L.; Peng, Z.F. A novel cysteine-free venom peptide with strong antimicrobial activity against antibioticsresistant pathogens from the scorpion Opistophthalmus glabrifrons. J. Pept. Sci. 2015, 21, 758–764. [Google Scholar] [CrossRef] [PubMed]
- Wu, S.F.; Nie, Y.; Zeng, X.C.; Cao, H.J.; Zhang, L.; Zhou, L.L.; Yang, Y.; Luo, X.S.; Liu, Y.C. Genomic and functional characterization of three new venompeptides from the scorpion Heterometrus spinifer. Peptides 2014, 53, 30–41. [Google Scholar] [CrossRef] [PubMed]
- Zhang, L.; Shi, W.X.; Zeng, X.C.; Ge, F.; Yang, M.K.; Nie, Y.; Bao, A.; Wu, S.F.; E, G.J. Unique diversity of the venom peptides from the scorpion Androctonus bicolor revealed by transcriptomic and proteomic analysis. J. Proteomics 2015, 128, 231–250. [Google Scholar] [CrossRef]
- Smith, J.J.; Hill, J.M.; Little, M.J.; Nicholson, G.M.; King, G.F.; Alewood, P.F. Unique scorpion toxin with a putative ancestral fold provides insight into evolution of the inhibitor cystine knot motif. Proc. Natl. Acad. Sci. USA 2011, 108, 10478–10483. [Google Scholar] [CrossRef]
- Rcr, D.L.V.; Possani, L.D. Current views on scorpion toxins specific for K+-channels. Toxicon 2004, 43, 865–875. [Google Scholar] [CrossRef]
- Zhong, J.; Zeng, X.C.; Zeng, X.; Nie, Y.; Zhang, L.; Wu, S.; Bao, A. Transcriptomic analysis of the venom glands from the scorpion Hadogenes troglodytes, revealed unique and extremely high diversity of the venom peptides. J. Proteomics 2016, 150, 40–62. [Google Scholar] [CrossRef]
- Lippens, G.; Najib, J.; Wodak, S.J.; Tartar, A. NMR sequential assignments and solution structure of chlorotoxin, a small scorpion toxin that blocks chloride channels. Biochemistry 1995, 34, 13–21. [Google Scholar] [CrossRef] [PubMed]
- Chagot, B.; Pimentel, C.; Dai, L.; Pil, J.; Tytgat, J.; Nakajima, T.; Corzo, G.; Darbon, H.; Ferrat, G. An unusual fold for potassium channel blockers: NMR structure of three toxins from the scorpion Opisthacanthus madagascariensis. Biochem. J. 2005, 388, 263–271. [Google Scholar] [CrossRef] [PubMed]
- Smith, J.J.; Vetter, I.; Lewis, R.J.; Peigneur, S.; Tytgat, J.; Lam, A.; Gallant, E.M.; Beard, N.A.; Alewooda, P.F.; Dulhuntycet, A.F. Multiple actions of φ-LITX-Lw1a on ryanodine receptors reveal a functional link between scorpion DDH and ICK toxins. Proc. Natl. Acad. Sci. USA 2013, 110, 8906–8911. [Google Scholar] [CrossRef] [PubMed]
- Fan, Z.; Cao, L.; He, Y.; Hu, J.; Di, Z.; Wu, Y.; Cao, Z. Ctriporin, a new anti-methicillin resistant Staphylococcus aureus peptide from the venom of the scorpion Chaerilus tricostatus. Antimicrob. Agents Chemother. 2011, 55, 5220–5229. [Google Scholar] [CrossRef] [PubMed]
- Zeng, X.C.; Corzo, G.; Hahin, R. Scorpion venom peptides without disulfide bridges. IUBMB Life 2005, 57, 13–21. [Google Scholar] [CrossRef] [PubMed]
- Zeng, X.C.; Li, W.X.; Wang, S.X.; Zhu, S.Y.; Luo, F. Precursor of a novel scorpion venom peptide (BmKn1) with no disulfide bridge from Buthus martensii Karsch. IUBMB Life 2008, 51, 117–120. [Google Scholar] [CrossRef]
- Heinen, T.E.; Da, V.A. Arthropod venoms and cancer. Toxicon 2011, 57, 497–511. [Google Scholar] [CrossRef]
- King, G.F. Venoms as a platform for human drugs: Translating toxins into therapeutics. Expert Opin. Biol. Ther. 2011, 11, 1469–1484. [Google Scholar] [CrossRef]
- Ma, Y.; Zhao, R.; He, Y.; Li, S.; Liu, J.; Wu, Y.; Cao, Z.; Li, W. Transcriptome analysis of the venom gland of the scorpion Scorpiops jendeki: Implication for the evolution of the scorpion venom arsenal. BMC Genom. 2009, 10, 290. [Google Scholar] [CrossRef]
- Diego-García, E.; Batista, C.V.; Garcia-Gomez, B.I.; Lucas, S.; Candido, D.M.; Gomez-Lagunas, F.; Possani, L.D. The Brazilian scorpion Tityus costatus Karsch: Genes, peptides and function. Toxicon 2005, 45, 273–283. [Google Scholar] [CrossRef]
- Kozminsky-Atias, A.; Bar-Shalom, A.; Mishmar, D.; Zilberberg, N. Assembling an arsenal, the scorpion way. BMC Evol. Biol. 2008, 8, 333. [Google Scholar] [CrossRef]
- Morgenstern, D.; Rohde, B.H.; King, G.F.; Tal, T.; Sher, D.; Zlotkin, E. The tale of a resting gland: transcriptome of a replete venom gland from the scorpion Hottentotta judaicus. Toxicon 2011, 57, 695–703. [Google Scholar] [CrossRef] [PubMed]
- Mao, Q.H.; Ruan, J.P.; Cai, X.T.; Lu, W.G.; Ye, J.; Yang, J.; Yang, Y.; Sun, X.Y.; Cao, J.L.; Cao, P. Antinociceptive effects of analgesic-antitumor peptide (AGAP), a neurotoxin from the scorpion Buthus martensii karsch, on formalin-induced inflammatory pain through a mitogen-activated protein kinases-dependent mechanism in mice. PLoS ONE 2013, 8, e78239. [Google Scholar] [CrossRef] [PubMed]
- Zeng, X.C.; Luo, F.; Li, W.X. Molecular dissection of venom from Chinese scorpion Mesobuthus martensii: Identification and characterization of four novel disulfide-bridged venom peptides. Peptides 2006, 27, 1745–1754. [Google Scholar] [CrossRef] [PubMed]
- Zhao, R.M.; Dai, H.; Qiu, S.; Li, T.; He, Y.W.; Ma, Y.B.; Chen, Z.Y.; Wu, Y.L.; Li, W.X.; Cao, Z.J. Sdpi, the first functionally characterized kunitz-type trypsin inhibitor from scorpion venom. PLoS ONE 2011, 6, e27548. [Google Scholar] [CrossRef]
Sample Availability: Samples of the compounds are not available from the authors. |

© 2018 by the authors. Licensee MDPI, Basel, Switzerland. This article is an open access article distributed under the terms and conditions of the Creative Commons Attribution (CC BY) license (http://creativecommons.org/licenses/by/4.0/).
Share and Cite
Shi, W.; He, P.; Zeng, X.-C.; Wu, W.; Chen, X. Inhibitory Effect of an Acidic Peptide on the Activity of an Antimicrobial Peptide from the Scorpion Mesobuthus martensii Karsch. Molecules 2018, 23, 3314. https://doi.org/10.3390/molecules23123314
Shi W, He P, Zeng X-C, Wu W, Chen X. Inhibitory Effect of an Acidic Peptide on the Activity of an Antimicrobial Peptide from the Scorpion Mesobuthus martensii Karsch. Molecules. 2018; 23(12):3314. https://doi.org/10.3390/molecules23123314
Chicago/Turabian StyleShi, Wanxia, Pengchen He, Xian-Chun Zeng, Weiwei Wu, and Xiaoming Chen. 2018. "Inhibitory Effect of an Acidic Peptide on the Activity of an Antimicrobial Peptide from the Scorpion Mesobuthus martensii Karsch" Molecules 23, no. 12: 3314. https://doi.org/10.3390/molecules23123314
APA StyleShi, W., He, P., Zeng, X.-C., Wu, W., & Chen, X. (2018). Inhibitory Effect of an Acidic Peptide on the Activity of an Antimicrobial Peptide from the Scorpion Mesobuthus martensii Karsch. Molecules, 23(12), 3314. https://doi.org/10.3390/molecules23123314

